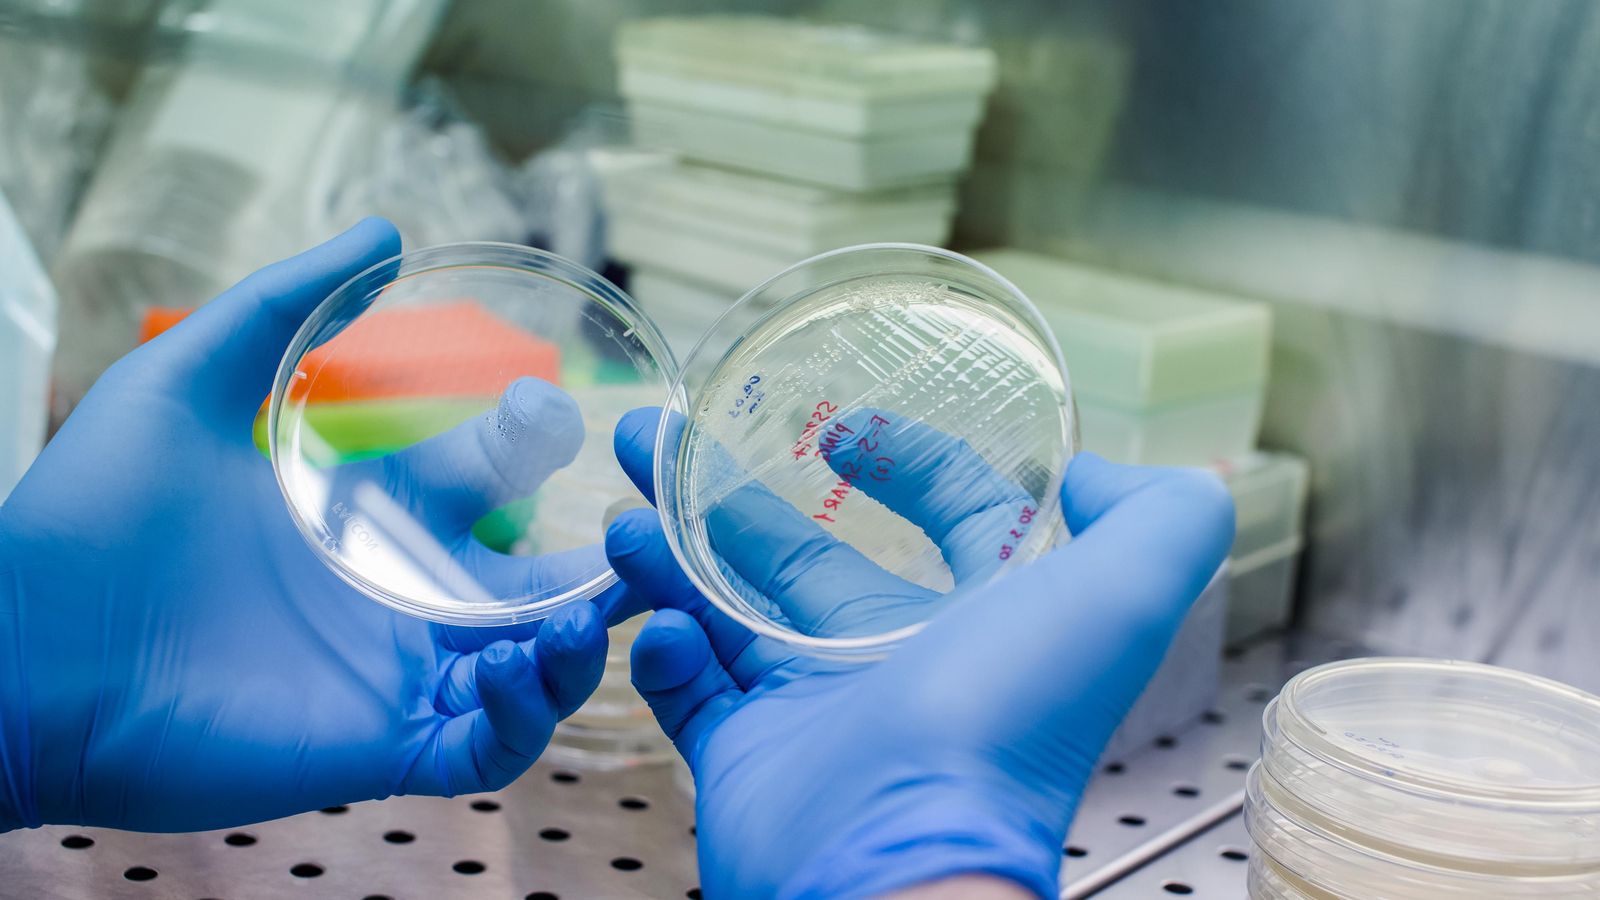
Una placa de Petri per a crear cèl·lules CAR-T (arxiu)

Nou avanç contra el càncer: una injecció aconsegueix generar cèl·lules CAR-T directament dins del cos
Una investigació estatunidenca usa una tècnica basada en tecnologia ARN i nanopartícules que demostra ser prometedora en malalties autoimmunes i obri la porta a tractaments més senzills contra alguns tumors malignes
La teràpia cel·lular CAR-T, que està revolucionant el tractament d'alguns càncers i malalties autoimmunes, pot continuar avançant amb un nou mètode que permet generar eixes estructures directament dins de l'organisme amb sols una injecció, sense necessitat d'entrenar-les fora del cos amb equipaments cars i sofisticats que no estan a l'abast de tothom. Un equip d'investigació estatunidenc liderat per Theresa L. Hunter publica en la revista Science un estudi en el qual presenta la tècnica, que demostra una reprogramació immunitària ràpida i sostinguda en models d'animals. Això la fa prometedora per a aconseguir avanços notables en els tractaments del càncer i les malalties autoimmunes.
Les conegudes com a teràpies CAR-T consisteixen a extraure una classe de glòbuls blancs del sistema immune del pacient, els limfòcits T, i entrenar-los perquè aprenguen a reconéixer i atacar les cèl·lules canceroses. Fins ara esta tècnica ha suposat una revolució en el tractament dels càncers de la sang, com ara la leucèmia i el limfoma. No obstant això, per a generar CAR-T cal extraure les cèl·lules del malalt, modificar-les genèticament en laboratori i tornar a introduir-les dins de l'organisme, per la qual cosa es tracta de teràpies costoses i que depenen d'una infraestructura mèdica molt especialitzada. La recerca encapçalada per Capstan Therapeutic i en la qual participa la Universitat de Pennsilvània, entre altres institucions, ha desenvolupat ara una estratègia que permet superar eixe obstacle.
La nova tècnica permet crear cèl·lules CAR-T directament dins del cos mitjançant una injecció que conté nanopartícules lipídiques dirigides (tLNP), les quals transporten directament als limfòcits T una càrrega d'ARN missatger (ARNm), un tipus de molècula que transporta informació genètica. És la mateixa tecnologia que usaven, per exemple, les vacunes d'ARN contra la covid-19. L'ús d'ARNm hauria d'evitar el risc d'alteració genètica permanent perquè, a diferència dels mètodes basats en l'ADN, l'ARNm no s'integra en el genoma de les cèl·lules T, resumeix Science.
Un obstacle important en l'administració d'ARNm amb nanopartícules lipídiques (LNP) és la tendència que tenen a ser absorbides pel sistema reticuloendotelial del fetge, que filtra les partícules estranyes del torrent sanguini. Per a intentar resoldre este obstacle, la investigació ha dissenyat un lípid específic que usen per a crear nanopartícules lipídiques dirigides a una proteïna concreta de la cèl·lula T, anomenada CD5. Quan es van provar en ratolins, rates i micos, estes nanopartícules lipídiques dirigides mostraren una captació hepàtica menor i un transport més precís a les cèl·lules T.
Per a avaluar l'eficàcia del sistema, s'empraren mostres de sang d'humans amb malalties autoimmunes i es va demostrar que les cèl·lules T derivades de pacients podien manipular-se amb una eficàcia semblant a les de donants sans, i que podien eliminar amb èxit les cèl·lules B dels pacients, que eren l'objectiu.
En models de ratolí empeltats amb cèl·lules immunitàries humanes, una sola dosi de les tLNP va provocar en qüestió d'hores una disminució ràpida i selectiva dels limfòcits B, amb efectes que van durar fins a dos setmanes. En un model experimental de xenoempelt de leucèmia —trasplantament d'una espècie a una altra diferent— l'administració repetida de les tLNP va produir una eliminació quasi completa del tumor, la qual cosa subratlla el potencial d'este enfocament in vivo per a tractar tant el càncer com les malalties autoimmunes, assenyala Science. L'equip indica en l'estudi que "en eliminar els requisits de la complexa fabricació ex vivo, esta plataforma tLNP té el potencial de fer que les teràpies amb cèl·lules CAR-T siguen més accessibles i aplicables altres indicacions clíniques".
